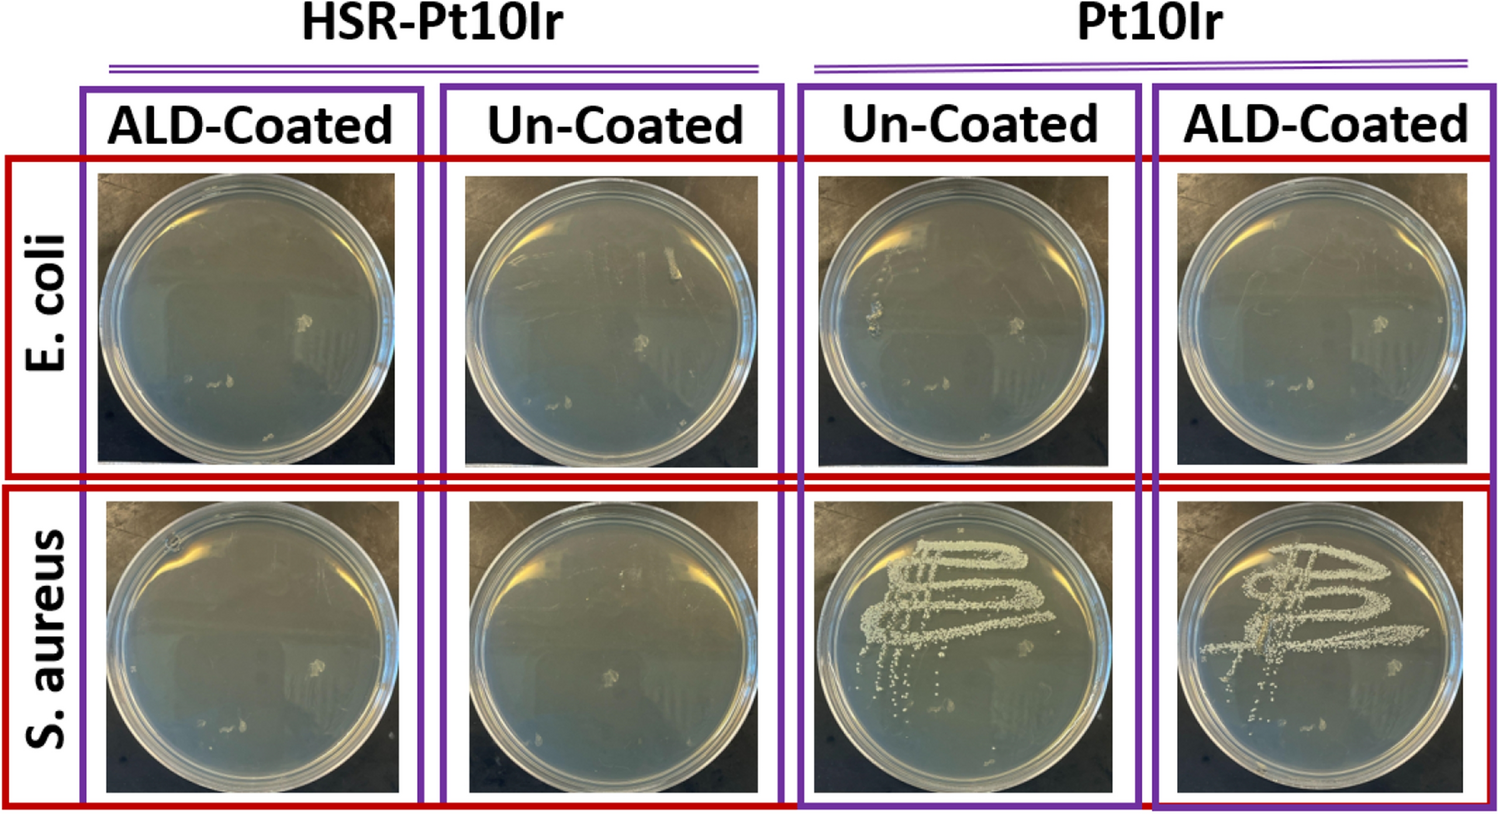
Figure 14

Figure 14

Bacterial surface and contact activities of each liquid culture (in LB) which contacted with the corresponding electrode: Agar plate analysis for the swabbing.
Bacterial surface and contact activities of each liquid culture (in LB) which contacted with the corresponding electrode: Agar plate analysis for the swabbing.